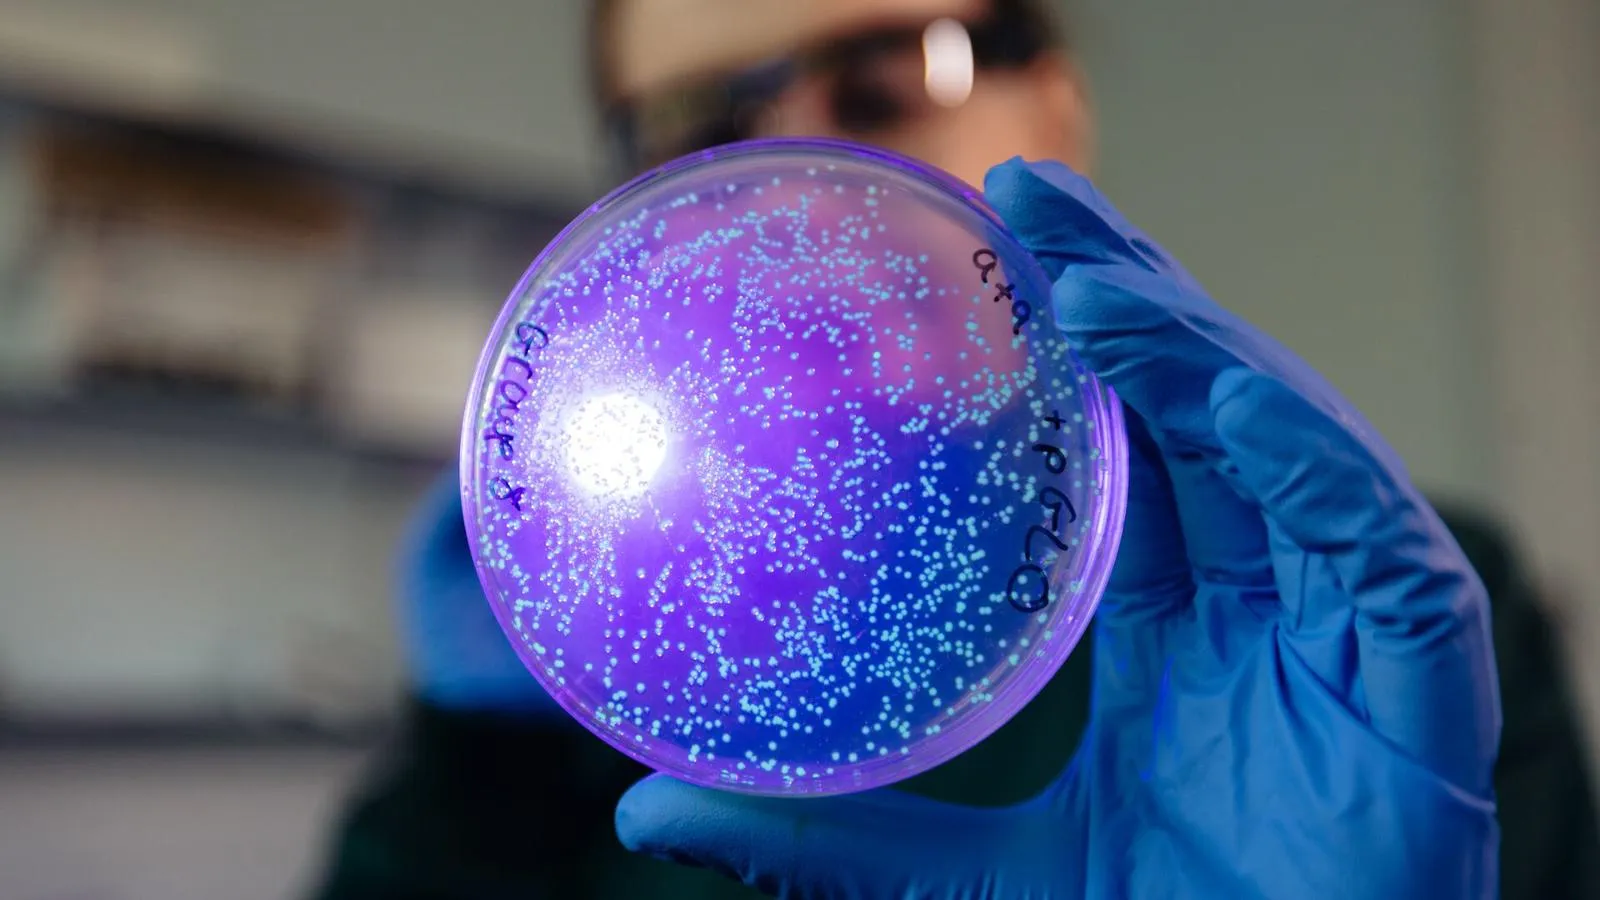
Biochemistry at the University of Hull

Biochemistry is the chemistry behind the complexity of life. By studying the fundamentals of chemistry and biology, you’ll understand the fascinating interface between the two and open up a range of career options.
You’ll be taught and inspired by biochemists, chemists and biologists – all experts in their field and recognised for their research in a range of topics including medical imaging, metabolic and cardiovascular diseases, wound healing, cancer, and lab-on-a-chip miniaturised biochemistry.
You can also opt to take a year abroad, studying overseas at one of our partner universities. Gain new skills, build international contacts, and immerse yourself in a different culture and environment.
About this course
Learn to apply your biochemical knowledge to provide solutions to some of society’s biggest challenges with this career-focused degree.
You’ll study core modules in the likes of microbiology, cellular biology, genetics and organic, inorganic and analytical chemistry, and then have the opportunity to tailor your course and develop your own special interests.
Our course includes a mixture of learning – such as theory, lab work and practical assignments – and you can also apply your skills in the real world thanks to our study abroad options and long-standing placement programme. We have connections with leading universities across the globe and strong links with industry, with students going to major companies such as Agilent, GSK, Reckitt and Smith & Nephew.
And thanks to our industry-standard facilities on campus, you’ll prepare for the work environment by honing your skills using the equipment you’ll utilise throughout your career.
Who runs the world? Microbes.
Module options
Each year, you’ll study modules worth a certain number of credits, and you need 120 credits per year. Most modules are 20 credits – so you’ll study six modules each year. Some longer modules, such as a dissertation, are worth more. In these cases, you’ll study fewer modules - but the number of credits will always add up to 120. Some modules are compulsory, some are optional, so you can build a course that’s right for you.
Filters
Microbiology
How does microbiology govern our world? In this module you will learn the basic principles of microbiology, before exploring the interplay between microbes, ourselves, and the wider environment.
compulsory
20 credits
Cells and Organelles
Explore the fascinating inner workings of cells, giving you a foundation in areas such as cell biology, molecular biology and biochemistry.
compulsory
20 credits
Molecular Biology and Genetics
DNA holds the secrets to life itself. Find out how key information is stored within the genes and the processes by which cells decode and interpret this genetic information to bring about essential cellular functions. You will discover how genetic information is inherited and what happens when things go wrong. Explore how molecular biology and genetic manipulation techniques allow us to uncover why genetic changes can lead to human disease and can potentially offer opportunities to diagnose and even treat them.Â
compulsory
20 credits
Analytical Techniques for Biochemistry
This module will develop your theoretical and practical awareness of fundamental analytical chemistry techniques relevant to biochemistry. You will learn mass spectrometry, spectroscopy, chromatography and data analysis through plenty of hands-on lab work to develop crucial problem solving and experimental skills.
compulsory
20 credits
Chemistry and Biochemistry: An Introduction
You will acquire skills in data collection, use computer packages to analyse data obtained from experimental work, understand how to set up experiments in chemistry, and gain awareness of health and safety in the laboratory. Knowledge and understanding of the chemical and physical principles in chemistry required in the second year of the degree programme will also be developed.
compulsory
20 credits
Evolution
Why did sex evolve? Why do we die? What is a species? How can evolutionary medicine help us? This module will provide you with an understanding of how life on earth came to be what it is, from genes to species. Without evolution, nothing in biology makes sense.
optional
20 credits
Human Physiology
Human Physiology will introduce you to the major physiological systems underpinning healthy human function. A range of topics on the workings of the human body are explored.
optional
20 credits
Metabolism
Examine the biological processes that allow the ‘symphony of life’ to occur. Understanding key metabolic concepts will further your understanding of biology itself, from human disease to the flow of energy through ecological systems so will feed in well with the other modules available to study.
compulsory
20 credits
Genetic Analysis
This module takes a problem-based approach to understanding modern Molecular Genetics and Genomics. Students will learn to participate in current debates and become accustomed with modern methods of laboratory investigation and genetic data analysis. A week-long laboratory session allows students to participate in current research and prepares them for careers in the molecular laboratory. This module focuses on Eukaryotes. It is also expected that students are already familiar with the basics of Genetics that was taught in Molecular Biology and Genetics.
compulsory
20 credits
Our facilities

Watchlist
Dr Samantha Richardson
Course overview
1 min
Flora Yeo
Student Story
2 mins
Smita Ghose
Student Story
2 mins
Extracting DNA
Course Highlight
2 mins
Teaching Facilities
University life
2 mins
Accommodation at Hull
University life
2 mins
Featured academics
We're tackling cancer and cardiovascular disease with the cutting-edge biomarker and medical imaging technologies we developed here at Hull, in collaboration with colleagues around the world.
We're committed to sharing our knowledge with and inspiring our students.

Andre Voelzmann
Lecturer in Cell Biology & Biotechnology
André joined the Faculty of Science and Engineering/Biological Sciences at the University where he is a Lecturer in Cell Biology. His research group explores host cell – virus interactions in the context of the manufacture of cell and gene therapies.
Entry Requirements
What do I need?
This course is currently available through Clearing, which means our entry requirements are a bit different to what they would normally be.
At Hull, you're a name not a number. During Clearing, we look at all of your qualifications and experience, not just your academic grades. We may be able to offer you a place whatever your situation. Get started by completing our eligibility checker, and find out immediately if you could study at the University of Hull.
Have questions? Our admissions team will be happy to help.
Fees & Funding
How much is it?

Future prospects
The analytical and lab skills you’ll develop here are highly valued by employers in the bioscience industry, as well as the biotech and pharmaceutical industries.
And our emphasis on collaboration and problem solving means you'll graduate with the skills to think and work as a scientist.
Plus, by creating the degree you want by selecting the modules that are most relevant to you and your interests, you’ll graduate with the specialist skills required for your chosen career.
Become part of the next generation of futuremakers
Like what you’ve seen? Then it’s time to apply.
The standard way to apply is through UCAS. This will give you the chance to showcase your skills, qualities and passion for the subject, as well as providing us with your academic qualifications.
Not ready to apply yet?
Visit our next Open Day, and see all that the University of Hull has to offer. Talk to our lecturers about your subject, find out what university is really like from our current students, and take a tour of our beautiful campus and amazing facilities.
You may also be interested in...
100% employability (Biochemistry) UK domicile full-time first degree leavers; Higher Education Graduate Outcomes statistics, for the academic year 2022/23, published by the Higher Education Statistics Agency June 2025.
Biology is ranked joint 3rd in the UK for Value Added Score. The Guardian University Rankings 2026.
All modules on this course page are subject to availability and this list may change at any time.